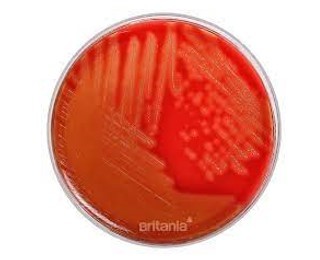
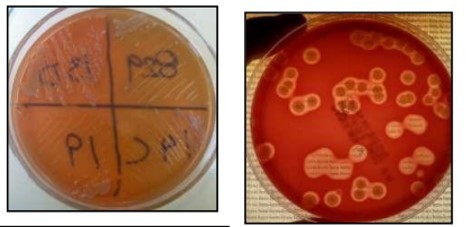
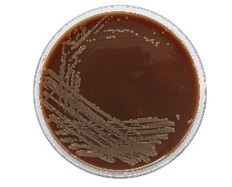
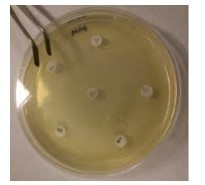
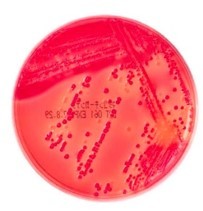
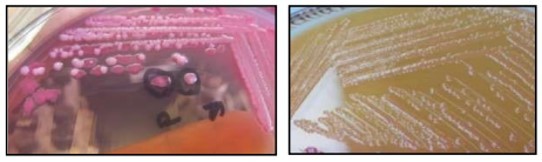
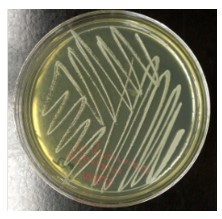
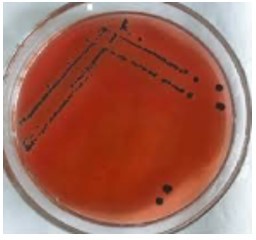

Que tipo de agar es
Agar sangre con hemolisis alfa (completa)
Tipo de agar
Que presenta
Segun utilidad es…
Agar sangre
Hemolisis gamma y beta
Tipo de agar
Segun su utilidad…
Agar chocolate
Enriquecido y no selectivo.
Tipo de agar
Segun su utilidad
Agar muller hilton
General y enriquecido
Tipo de agar
Segun su utilidad
Caracteristicas
Agar Mac Conkey
Selectivo y diferencial
Permite ver si hay fermetacion de lactosa
Tipo de agar
Se observa…
Agar MacConkey
Fermetacion de lactora
No fermetacion de lactosa
Tipo de agar
Segun su utilidad
Que significa
Agar TSA
General
No tiene inhibidores funciona para cualquier bacteria
Tipo de agar
Segun su utilidad
Para bacterias
Agar XLB
Selectivo
Salmonella y Shigella
¿Que es el factor de virulencia?
Todo mecanismo o estructura que utilice la bacteria y en forma de conjunto contra ataque, de esta manera se da la patología.
Fases de infección:
Requisitos para la infección:
Vías de entrada:
Rango de temperatura optima:
Que bacterias nos afectan
MESOFILAS
Aerobia obligada
Requiere oxigeno
Anaeróbico facultativo
Anaeróbico aerotolerante
Anaeróbico estricto
Microaerófilo
Cuando la cantidad de oxigeno dentro y fuera favorece a la bacteria (presion)
Fases de la curva de crecimiento:
Fase de latencia: Cuando uno inocula en un medio una cantidad determinada de bacterias y esa cantidad se mantiene en el tiempo sea más largo o corto, dependiendo de su adaptación.
Fase Exponencial : Definición de rutas metabólicas y los sustratos adecuados para dicha bacteria (incremento de bacterias).
Fase Estacionaria: Cuando empiezan a agotarse los nutrientes, conocido como nutriente limitado (población constante). En esta etapa el numero de bacterias que vive es igual al numero de bacterias que mueren.
Fase de muerte: Cuando se acaba el sustrato.
Medio de transporte según estado físico
Medio de transporte según utilidad:
Fundamento de la Tinción Simple
Observar en el microscopio
Fundamento de la tincion GRAM
De que color es la gram - y gram + respectivamente
ROSADO
MORADO